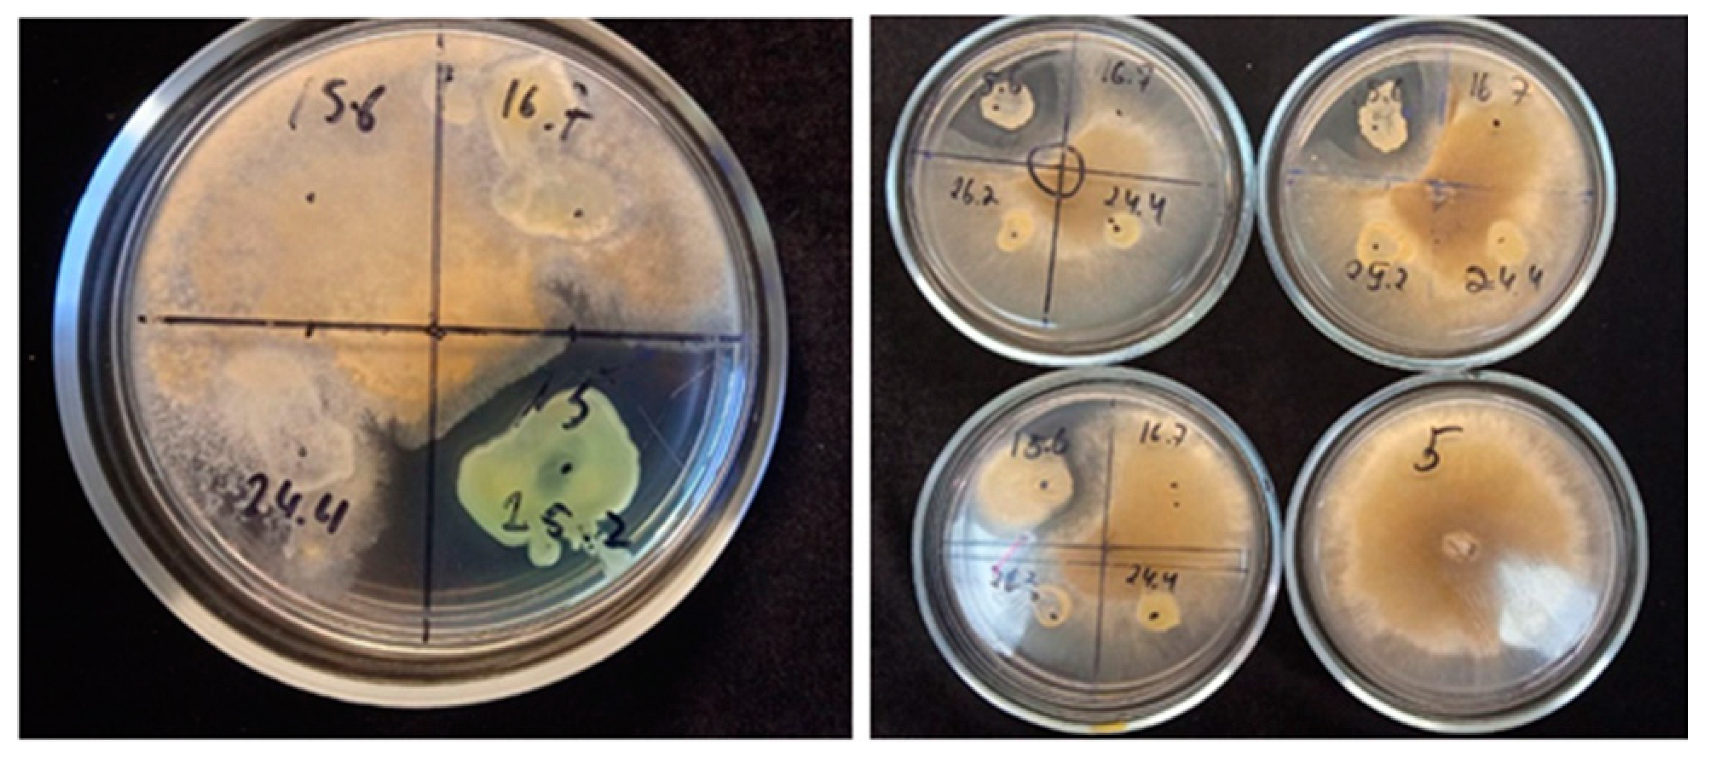

Endophytic Bacterial Biofilm-Formers Associated with Antarctic Vascular Plants
Abstract
1. Introduction
2. Materials and Methods
3. Results
3.1. Identification and Phylogenetic Analysis
- −
- The Pseudomonas species (24.4, 10.1, 26.2), Hafnia sp. 25.2, and Psychrobacter arcticus 10.4;
- −
- Arthrobacter psychrochitiniphilus 15.6 and 16.7, Pseudarthrobacter sp. 26.7, Kocuria salsicia 40.1, Agreia sp. 23.2, and Siminovitchia terrae 9.1;
- −
- Brachybacterium sp. 39.12.
3.2. Saccharolytic Enzymes of Bacterial Isolates
3.3. Plant Growth-Promoting Traits
3.4. Salt and Oligotrophic Environment Tolerance
3.5. Antifungal Activity
3.6. Biofilm Growth and Structure
- −
- Siminovitchia terrae 9.1 (Figure 6A) forms a thick aggregate (on average, 32 µm thick) of cellulose fibers and cell clusters strongly intertwined. The biofilm profile was dispersed, and only low amyloid contents were found in this biofilm.
- −
- Pseudomonas salomonii 10.1 (Figure 6B) forms a dense biofilm with high levels of amyloid and eDNA, and relatively low cellulose content.
- −
- An example of a mucous biofilm profile is biofilm formed by Arthrobacter psychrochitiniphilus 15.6 (Figure 6C) with high cellulose and eDNA content, and almost no amyloids. The cellulose aggregates into ball-shaped structures penetrating the whole biofilm but not intertwined with cells as was observed in P. salomonii (Figure 6B).
4. Discussion
4.1. Novel Species
4.2. Cluster Analysis
4.3. Plant Growth-Promoting Properties of Antarctic Bacteria
4.4. Salt Tolerance
4.5. Biofilm Structure and Physiology
5. Conclusions
Author Contributions
Funding
Data Availability Statement
Conflicts of Interest
References
- Alberdi, M.; Bravo, L.A.; Gutiérrez, A.; Gidekel, M.; Corcuera, L.J. Ecophysiology of Antarctic vascular plants. Physiol. Plant. 2002, 115, 479–486. [Google Scholar] [CrossRef] [PubMed]
- Znój, A.; Gawor, J.; Gromadka, R.; Chwedorzewska, K.J.; Grzesiak, J. Root-associated bacteria community characteristics of Antarctic plants: Deschampsia antarctica and Colobanthus quitensis—A comparison. Microb. Ecol. 2022, 84, 808–820. [Google Scholar] [CrossRef] [PubMed]
- Parnikoza, I.; Kozeretska, I.; Kunakh, V. Vascular plants of the Maritime Antarctic: Origin and adaptation. Am. J. Plant Sci. 2011, 2, 381. [Google Scholar] [CrossRef]
- Ganzert, L.; Bajerski, F.; Mangelsdorf, K.; Lipski, A.; Wagner, D. Arthrobacter livingstonensis sp. nov. and Arthrobacter cryotolerans sp. nov., salt-tolerant and psychrotolerant species from Antarctic soil. Int. J. Syst. Evol. Microbiol. 2011, 61, 979–984. [Google Scholar] [CrossRef]
- Gallardo-Cerda, J.; Levihuan, J.; Lavín, P.; Oses, R.; Atala, C.; Torres-Díaz, C.; Molina-Montenegro, M.A. Antarctic rhizobacteria improve salt tolerance and physiological performance of the Antarctic vascular plants. Polar Biol. 2018, 41, 1973–1982. [Google Scholar] [CrossRef]
- Araya, M.A.; Valenzuela, T.; Inostroza, N.G.; Maruyama, F.; Jorquera, M.A.; Acuña, J.J. Isolation and characterization of cold-tolerant hyper-ACC-degrading bacteria from the rhizosphere, endosphere, and phyllosphere of Antarctic vascular plants. Microorganisms 2020, 8, 1788. [Google Scholar] [CrossRef]
- Mojib, N.; Farhoomand, A.; Andersen, D.T.; Bej, A.K. UV and cold tolerance of a pigment-producing Antarctic Janthinobacterium sp. Ant5-2. Extremophiles 2013, 17, 367–378. [Google Scholar] [CrossRef]
- Shin, Y.; Lee, B.H.; Lee, K.E.; Park, W. Pseudarthrobacter psychrotolerans sp. nov., a cold-adapted bacterium isolated from Antarctic soil. Int. J. Syst. Evol. Microbiol. 2020, 70, 6106–6114. [Google Scholar] [CrossRef]
- Louca, S.; Polz, M.F.; Mazel, F.; Albright, M.B.; Huber, J.A.; O’Connor, M.I.; Ackermann, M.; Hahn, A.S.; Srivastava, D.S.; Crowe, S.A.; et al. Function and functional redundancy in microbial systems. Nat. Ecol. Evol. 2018, 2, 936–943. [Google Scholar] [CrossRef]
- Bashir, I.; War, A.F.; Rafiq, I.; Reshi, Z.A.; Rashid, I.; Shouche, Y.S. Phyllosphere microbiome: Diversity and functions. Microbiol. Res. 2022, 254, 126888. [Google Scholar] [CrossRef]
- Mishra, S.; Bhattacharjee, A.; Sharma, S. An ecological insight into the multifaceted world of plant-endophyte association. Crit. Rev. Plant Sci. 2021, 40, 127–146. [Google Scholar] [CrossRef]
- Brader, G.; Compant, S.; Vescio, K.; Mitter, B.; Trognitz, F.; Ma, L.J.; Sessitsch, A. Ecology and genomic insights into plant-pathogenic and plant-nonpathogenic endophytes. Annu. Rev. Phytopathol. 2017, 55, 61–83. [Google Scholar] [CrossRef] [PubMed]
- Compant, S.; Cambon, M.C.; Vacher, C.; Mitter, B.; Samad, A.; Sessitsch, A. The plant endosphere world–bacterial life within plants. Environ. Microbiol. 2021, 23, 1812–1829. [Google Scholar] [CrossRef] [PubMed]
- Pankievicz VC, S.; do Amaral, F.P.; Ané, J.M.; Stacey, G. Diazotrophic bacteria and their mechanisms to interact and benefit cereals. Mol. Plant-Microbe Interact. 2021, 34, 491–498. [Google Scholar] [CrossRef]
- Narayanan, Z.; Glick, B.R. Secondary metabolites produced by plant growth-promoting bacterial endophytes. Microorganisms 2022, 10, 2008. [Google Scholar] [CrossRef]
- Pitiwittayakul, N.; Tanasupawat, S. Plant growth-promoting endophytic bacteria and their potential benefits in Asian countries. In Beneficial Microbes for Sustainable Agriculture and Environmental Management; Apple Academic Press: Williston, VT, USA, 2020; pp. 81–114. [Google Scholar]
- Schultz, J.; Rosado, A.S. Microbial role in the ecology of Antarctic plants. In The Ecological Role of Micro-Organisms in the Antarctic Environment; Springer: Cham, Switzerland, 2019; pp. 257–275. [Google Scholar]
- de Garcia Salamone, I.E.; Hynes, R.K.; Nelson, L.M. Role of cytokinins in plant growth promotion by rhizosphere bacteria. In PGPR: Biocontrol Biofertilization; Springer: Berlin/Heidelberg, Germany, 2006; pp. 173–195. [Google Scholar]
- Afzal, I.; Shinwari, Z.K.; Sikandar, S.; Shahzad, S. Plant beneficial endophytic bacteria: Mechanisms, diversity, host range and genetic determinants. Microbiol. Res. 2019, 221, 36–49. [Google Scholar] [CrossRef]
- Kumar, A.; Singh, J. Biofilms forming microbes: Diversity and potential application in plant–microbe interaction and plant growth. In Plant Microbiomes for Sustainable Agriculture; Springer: Berlin/Heidelberg, Germany, 2020; pp. 173–197. [Google Scholar]
- Li, Y.; Narayanan, M.; Shi, X.; Chen, X.; Li, Z.; Ma, Y. Biofilms formation in plant growth-promoting bacteria for alleviating agro-environmental stress. Sci. Total Environ. 2023, 907, 167774. [Google Scholar] [CrossRef]
- Barcikowski, A.; Czaplewska, J.; Giełwanowska, I.; Loro, P.; Smyka, J. Deschampsia antarctica (Poaceae)—The only native grass from Antarctica. In Studies on Grasses in Poland; Frey, L., Ed.; W. Szafer Institute of Botany, Polish Academy of Sciences: Kraków, Poland, 2001; pp. 367–377. [Google Scholar]
- Mantovani, A.; Cardoso Vieira, R. Leaf micromorphology of Antarctic pearlwort Colobanthus quitensis (Kunth) Bartl. Polar Biol. 2000, 23, 531–538. [Google Scholar] [CrossRef]
- Barra, P.J.; Inostroza, N.G.; Acuña, J.J.; Mora, M.L.; Crowley, D.E.; Jorquera, M.A. Formulation of bacterial consortia from avocado (Persea americana Mill.) and their effect on growth, biomass and superoxide dismutase activity of wheat seedlings under salt stress. Appl. Soil Ecol. 2016, 102, 80–91. [Google Scholar] [CrossRef]
- Prekrasna, I.; Dzhulai, A.; Parnikoza, I. Preliminary estimates of the number and diversity of the culturable endophytic bacteria from Deschampsia antarctica and Colobanthus quitensis. Visn. Ukr. Kogo Tov. Genet. Sel. 2021, 19, 21–30. [Google Scholar] [CrossRef]
- Prekrasna, I.; Pavlovska, M.; Miryuta, N.; Dzhulai, A.; Dykyi, E.; Convey, P.; Parnikoza, I. Antarctic hairgrass rhizosphere microbiomes: Microscale effects shape diversity, structure, and function. Microbes Environ. 2022, 37, ME21069. [Google Scholar] [CrossRef]
- Andrews, S. FastQC: A Quality Control Tool for High Throughput Sequence Data. 2010. Available online: http://www.bioinformatics.babraham.ac.uk/projects/fastqc/ (accessed on 11 August 2021).
- Wick, R.R.; Judd, L.M.; Gorrie, C.L.; Holt, K.E. Unicycler: Resolving bacterial genome assemblies from short and long sequencing reads. PLoS Comput. Biol. 2017, 13, e1005595. [Google Scholar] [CrossRef]
- Seemann, T. barrnap 0.9: Rapid Ribosomal RNA Prediction. 2013. Available online: https://mybiosoftware.com/barrnap-bacterial-ribosomal-rna-predictor.html (accessed on 14 August 2021).
- Thavasi, R.; Sharma, S.; Jayalakshmi, S. Evaluation of screening methods for the isolation of biosurfactant producing marine bacteria. J. Pet Environ. Biotechnol. S 2011, 1, 1–7. [Google Scholar] [CrossRef]
- Vazquez, S.C.; Rios Merino, L.N.; MacCormack, W.P.; Fraile, E.R. Protease-producing psychrotrophic bacteria isolated from Antarctica. Polar Biol. 1995, 15, 131–135. [Google Scholar] [CrossRef]
- Nath, D.; Maurya, B.R.; Meena, V.S. Documentation of five potassium-and phosphorus-solubilizing bacteria for their K and P-solubilization ability from various minerals. Biocatal. Agric. Biotechnol. 2017, 10, 174–181. [Google Scholar] [CrossRef]
- Pande, A.; Pandey, P.; Mehra, S.; Singh, M.; Kaushik, S. Phenotypic and genotypic characterization of phosphate solubilizing bacteria and their efficiency on the growth of maize. J. Genet. Eng. Biotechnol. 2017, 15, 379–391. [Google Scholar] [CrossRef]
- Suslova, O.; Govorukha, V.; Brovarskaya, O.; Matveeva, N.; Tashyreva, H.; Tashyrev, O. Method for determining organic compound concentration in bio-logical systems by permanganate redox titration. Int. J. Bioautomation 2014, 18, 45. [Google Scholar]
- Elkahoui, S.; Djébali, N.; Tabbene, O.; Hadjbrahim, A.; Mnasri, B.; Mhamdi, R.; Limam, F. Evaluation of antifungal activity from Bacillus strains against Rhizoctonia solani. Afr. J. Biotechnol. 2012, 11, 4196–4201. [Google Scholar]
- Xu, Z.; Liang, Y.; Lin, S.; Chen, D.; Li, B.; Li, L.; Deng, Y. Crystal violet and XTT assays on Staphylococcus aureus biofilm quantification. Curr. Microbiol. 2016, 73, 474–482. [Google Scholar] [CrossRef]
- Maechler, M.; Rousseeuw, P.; Struyf, A.; Hubert, M.; Hornik, K. Cluster: Cluster Analysis Basics and Extensions, R package Version 2.1.4. 2022.
- Torsvik, V.; Øvreås, L. Microbial diversity, life strategies, and adaptation to life in extreme soils. In Microbiology of Extreme Soils; Springer: Berlin/Heidelberg, Germany, 2008; pp. 15–43. [Google Scholar]
- Iungin, O.; Prekrasna-Kviatkovska, Y.; Kalinichenko, O.; Savchuk, Y.; Krainova, Y.; Sidorenko, M.; Mickevičius, S. Antifungal activity of endophytic bacteria associated with Antarctic vascular plants. In Proceedings of the 10th International Conference on Advanced Materials and Systems, ICAMS 2024, Bucharest, Romania, 30–31 October 2024. [Google Scholar]
- Vaughan, D.G.; Doake, C.S.M. Recent atmospheric warming and retreat of ice shelves on the Antarctic Peninsula. Nature 1996, 379, 328–331. [Google Scholar] [CrossRef]
- Parnikoza, I.Y.; Berezkina, A.; Moiseyenko, Y.; Malanchuk, V.; Kunakh, V. Kompleksna harakterystyka rajonu Argentynskih Ostroviv ta Ostrova Galindez (morska Antarktyka) jak poligonu dlja vyvčennja dynamiki nazemnoji roslynnosti. (Complex survey of the Argentine Islands and Galindez Island [maritime Antarctic] as a research area for studying the dynamics of terrestrial vegetation.). Ukr. Antarct. J. 2018, 17, 73–101, (In Ukrainian with English abstract on the website). [Google Scholar] [CrossRef]
- Komárková, V.; Poncet, S.; Poncet, J. Two Native Antarctic Vascular Plants, Deschampsia antarctica and Colobanthus quitensis: A New Southernmost Locality and Other Localities in the Antarctic Peninsula Area. Arct. Alp. Res. 1985, 17, 401–416. [Google Scholar] [CrossRef]
- Podolich, O.; Prekrasna, I.; Parnikoza, I.; Voznyuk, T.; Zubova, G.; Zaets, I.; Miryuta, N.; Myryuta, G.; Poronnik, O.; Kozeretska, I.; et al. First record of the endophytic bacteria of Deschampsia antarctica Ė. Desv. from two distant localities of the maritime Antarctic. Czech Polar Rep. 2021, 11, 134–153. [Google Scholar] [CrossRef]
- Zhang, Z.H.; Jhaveri, D.J.; Marshall, V.M.; Bauer, D.C.; Edson, J.; Narayanan, R.K.; Robinson, G.J.; Lundberg, A.E.; Bartlett, P.F.; Wray, N.R.; et al. A comparative study of techniques for differential expression analysis on RNA-Seq data. PLoS ONE 2014, 9, e103207. [Google Scholar] [CrossRef]
- Park, M.; Lee, H.; Hong, S.G.; Kim, O.S. Endophytic bacterial diversity of an Antarctic moss, Sanionia uncinata. Antarct. Sci. 2013, 25, 51–54. [Google Scholar] [CrossRef]
- Lee, Y.M.; Kim, E.H.; Lee, H.K.; Hong, S.G. Biodiversity and physiological characteristics of Antarctic and Arctic lichens-associated bacteria. World J. Microbiol. Biotechnol. 2014, 30, 2711–2721. [Google Scholar] [CrossRef]
- Glick, B.R. Plant growth-promoting bacteria: Mechanisms and applications. Scientifica 2012, 2012, 963401. [Google Scholar] [CrossRef]
- Vasquez YM, S.C.; Gomes, M.B.; e Silva, T.R.; Duarte AW, F.; Rosa, L.H.; de Oliveira, V.M. Cold-adapted chitinases from Antarctic bacteria: Taxonomic assessment and enzyme production optimization. Biocatal. Agric. Biotechnol. 2021, 34, 102029. [Google Scholar]
- Ribeiro ID, A.; Volpiano, C.G.; Vargas, L.K.; Granada, C.E.; Lisboa, B.B.; Passaglia, L.M.P. Use of mineral weathering bacteria to enhance nutrient availability in crops: A review. Front. Plant Sci. 2020, 11, 590774. [Google Scholar] [CrossRef]
- Gamalero, E.; Glick, B.R. Mechanisms used by plant growth-promoting bacteria. In Bacteria in Agrobiology: Plant Nutrient Management; Springer: Berlin/Heidelberg, Germany, 2011; pp. 17–46. [Google Scholar]
- Sabkia, M.H.; Ongb, P.Y.; Ibrahimc, N.; Leea, C.T.; Klemešd, J.J.; Lie, C.; Gaoe, Y. A review on abiotic stress tolerance and plant growth metabolite framework by plant growth-promoting bacteria for sustainable agriculture. Chem. Eng. Trans. 2021, 83, 367–372. [Google Scholar]
- Khatoon, Z.; Huang, S.; Farooq, M.A.; Santoyo, G.; Rafique, M.; Javed, S.; Gul, B. Role of plant growth-promoting bacteria (PGPB) in abiotic stress management. Mitig. Plant Abiotic Stress By Microorg. 2022, 257–272. [Google Scholar] [CrossRef]
- Turan, M.; Arjumend, T.; Argın, S.; Yıldırım, E.; Katırcıoğlu, H.; Gürkan, B.; Bolouri, P. Plant root enhancement by plant growth promoting rhizobacteria. In Plant Roots; Books on Demand: Norderstedt, Germany, 2021. [Google Scholar]
- Singh, M.; Singh, D.; Gupta, A.; Pandey, K.D.; Singh, P.K.; Kumar, A. Plant growth promoting rhizobacteria: Application in biofertilizers and biocontrol of phytopathogens. In PGPR Amelioration in Sustainable Agriculture; Woodhead Publishing: Cambridge, UK, 2019; pp. 41–66. [Google Scholar]
- Abdelaal, K.; AlKahtani, M.; Attia, K.; Hafez, Y.; Király, L.; Künstler, A. The role of plant growth-promoting bacteria in alleviating the adverse effects of drought on plants. Biology 2021, 10, 520. [Google Scholar] [CrossRef]
- Cherkasov, N.; Ibhadon, A.O.; Fitzpatrick, P. A review of the existing and alternative methods for greener nitrogen fixation. Chem. Eng. Process. Process Intensif. 2015, 90, 24–33. [Google Scholar] [CrossRef]
- Billah, M.; Khan, M.; Bano, A.; Hassan, T.U.; Munir, A.; Gurmani, A.R. Phosphorus and phosphate solubilizing bacteria: Keys for sustainable agriculture. Geomicrobiol. J. 2019, 36, 904–916. [Google Scholar] [CrossRef]
- Omidvari, M.; Abbaszadeh-Dahaji, P.; Hatami, M.; Kariman, K. Biocontrol: A novel eco-friendly mitigation strategy to manage plant diseases. Plant Stress Mitigators 2023, 27–56. [Google Scholar] [CrossRef]
- Balleza, D.; Alessandrini, A.; Beltrán García, M.J. Role of Lipid Composition, Physicochemical Interactions, and Membrane Mechanics in the Molecular Actions of Microbial Cyclic Lipopeptides. J. Membr. Biol. 2019, 252, 131–157. [Google Scholar] [CrossRef]
- Aleti, G.; Lehner, S.; Bacher, M.; Compant, S.; Nikolic, B.; Plesko, M.; Brader, G. Surfactin variants mediate species-specific biofilm formation and root colonization in Bacillus. Environ. Microbiol. 2016, 18, 2634–2645. [Google Scholar] [CrossRef]
- Ramlawi, S.; Abusharkh, S.; Carroll, A.; McMullin, D.R.; Avis, T.J. Biological and chemical characterization of antimicrobial activity in Arthrobacter spp. isolated from disease-suppressive compost. J. Basic Microbiol. 2021, 61, 745–756. [Google Scholar] [CrossRef]
- Paul, N.C.; Ji, S.H.; Deng, J.X.; Yu, S.H. Assemblages of endophytic bacteria in chili pepper (Capsicum annuum L.) and their antifungal activity against phytopathogens in vitro. Plant Omics 2013, 6, 441–448. [Google Scholar]
- Velázquez-Becerra, C.; Macías-Rodríguez, L.I.; López-Bucio, J.; Flores-Cortez, I.; Santoyo, G.; Hernández-Soberano, C.; Valencia-Cantero, E. The rhizobacterium Arthrobacter agilis produces dimethylhexadecylamine, a compound that inhibits growth of phytopathogenic fungi in vitro. Protoplasma 2013, 250, 1251–1262. [Google Scholar] [CrossRef]
- Ramlawi, S. Characterization of Bioactivity and Antimicrobial Metabolite Production in Bacteria Antagonistic to Plant and Foodborne Molds. Ph.D. Thesis, Carleton University, Ottawa, ON, Canada, 2021. [Google Scholar]
- Zheng, H.; Zhang, P.; Qin, J.; Guo, J.; Deng, J. High-throughput sequencing-based analysis of the composition and diversity of endophytic bacteria community in tubers of Gastrodia elata f. glauca. Front. Microbiol. 2023, 13, 1092552. [Google Scholar] [CrossRef] [PubMed]
- Jansen, M.A.; Potters, G. Stress: The way of life. In Plant Stress Physiology, 2nd ed.; Shabala, S., Ed.; CABI: Wallingford, UK, 2017; pp. ix–xiv. [Google Scholar]
- Reang, L.; Bhatt, S.; Tomar, R.S.; Joshi, K.; Padhiyar, S.; Vyas, U.M.; Kheni, J.K. Plant growth promoting characteristics of halophilic and halotolerant bacteria isolated from coastal regions of Saurashtra Gujarat. Sci. Rep. 2022, 12, 4699. [Google Scholar] [CrossRef] [PubMed]
- Campbell, I.B.; Claridge, G.G.C. Antarctica: Soils, Weathering Processes and Environment; Elsevier: Amsterdam, The Netherlands, 1987. [Google Scholar]
- George, S.F.; Fierer, N.; Levy, J.S.; Adams, B. Antarctic water tracks: Microbial community responses to variation in soil moisture, pH, and salinity. Front. Microbiol. 2021, 12, 616730. [Google Scholar] [CrossRef] [PubMed]
- Moshynets, O.V.; Pokholenko, I.; Iungin, O.; Potters, G.; Spiers, A.J. eDNA, Amyloid fibers and membrane vesicles identified in Pseudomonas fluorescens SBW25 biofilms. Int. J. Mol. Sci. 2022, 23, 15096. [Google Scholar] [CrossRef]
- Martins, M.; Uppuluri, P.; Thomas, D.P.; Cleary, I.A.; Henriques, M.; Lopez-Ribot, J.L.; Oliveira, R. Presence of extracellular DNA in the Candida albicans biofilm matrix and its contribution to biofilms. Mycopathologia 2010, 169, 323–331. [Google Scholar] [CrossRef]
- Moshynets, O.V.; Baranovskyi, T.P.; Iungin, O.S.; Kysil, N.P.; Metelytsia, L.O.; Pokholenko, I.; Rogalsky, S.P. eDNA inactivation and biofilm inhibition by the PolymericBiocide polyhexamethylene guanidine hydrochloride (PHMG-Cl). Int. J. Mol. Sci. 2022, 23, 731. [Google Scholar] [CrossRef]
- Buzzo, J.R.; Devaraj, A.; Gloag, E.S.; Jurcisek, J.A.; Robledo-Avila, F.; Kesler, T.; Goodman, S.D. Z-form extracellular DNA is a structural component of the bacterial biofilm matrix. Cell 2021, 184, 5740–5758. [Google Scholar] [CrossRef]
- Luheshi, L.M.; Tartaglia, G.G.; Brorsson, A.C.; Pawar, A.P.; Watson, I.E.; Chiti, F.; Crowther, D.C. Systematic in vivo analysis of the intrinsic determinants of amyloid β pathogenicity. PLoS Biol. 2007, 5, e290. [Google Scholar] [CrossRef]
- Li, D.; Liu, C. Conformational strains of pathogenic amyloid proteins in neurodegenerative diseases. Nat. Rev. Neurosci. 2022, 23, 523–534. [Google Scholar] [CrossRef]
- Gebbink, M.F.; Claessen, D.; Bouma, B.; Dijkhuizen, L.; Wösten, H.A. Amyloids—A functional coat for microorganisms. Nat. Rev. Microbiol. 2005, 3, 333–341. [Google Scholar] [CrossRef]
- Gómez-Pérez, D.; Chaudhry, V.; Kemen, A.; Kemen, E. Amyloid proteins in plant-associated microbial communities. Microb. Physiol. 2021, 31, 88–98. [Google Scholar] [CrossRef] [PubMed]

| Number of Sample | Sampling Location | Plant | Isolate Number | Coordinates |
|---|---|---|---|---|
| 1 | Lahille Island | D. antarctica | 9.1 | −65.553580°, −64.394883° |
| 2 | Lahille Island | C. quitensis | 10.1, 10.4 | −65.553580°, −64.394883° |
| 3 | Ronge Island | D. antarctica | 15.6, 16.7 | −64.683430°, −62.644170° |
| 4 | Santos Peak, Graham Passage | D. antarctica | 23.2, 24.4 | −64.405750°, −61.547410° |
| 5 | Galindez Island, Argentine Islands | D. antarctica | 25.2, 26.2, 26.7 | −65.244807°, −64.255709° |
| 6 | Lagotellerie Island | C. quitensis | 39.12 | −67.88486°, −67.38765° |
| 7 | Lagotellerie Island | D. antarctica | 40.1 | −67.88486°, −67.38765° |
| Strain Number | Species Name | Monosaccharides | Disaccharides | |||||||
|---|---|---|---|---|---|---|---|---|---|---|
| Hexoses | Pentoses | |||||||||
| Glu | Fru | Man | Gal | Ara | Xyl | Ryb | Lac | Suc | ||
| 9.1 | Siminovitchia terrae | + | - | + | - | - | - | - | - | - |
| 10.1 | Pseudomonas salomonii | + | - | + | + | - | + | + | - | - |
| 10.4 | Psychrobacter arcticus | + | - | + | + | - | + | + | - | - |
| 15.6 | Arthrobacter psychrochitiniphilus | + | - | - | - | - | + | - | - | - |
| 16.7 | Arthrobacter psychrochitiniphilus | + | - | - | - | + | + | - | + | + |
| 23.2 | Agreia sp. | + | + | + | - | + | + | - | + | + |
| 24.4 | Pseudomonas yamanorum | + | - | + | + | - | + | - | - | + |
| 25.2 | Hafnia sp. | + | + | + | + | - | + | + | + | + |
| 26.2 | Pseudomonas sp. | + | - | + | + | - | + | - | - | +- |
| 26.7 | Pseudarthrobacter sp. | + | + | + | - | - | - | + | +- | + |
| 39.12 | Brachybacterium sp. | + | + | - | - | - | - | + | - | - |
| 40.1 | Kocuria salsicia | + | + | + | + | + | + | + | +- | + |
| Strain Number | Species Name | Growth on NF Media | Phosphate Solubilization Index (PSI) | BSFs | Motility | IAA (µg/mL) | HCN | |
|---|---|---|---|---|---|---|---|---|
| OD600 | CFU Number | |||||||
| 9.1 | Siminovitchia terrae | 0.031 ± 0.003 | - | 1.35 ± 0.02 | - | + | - | - |
| 10.1 | Pseudomonas salomonii | 0.052 ± 0.011 | 106 | 2.0 ± 0.01 | + | + | - | - |
| 10.4 | Psychrobacter arcticus | 0.047 ± 0.006 | 104 | 3.23 ± 0.52 | + | - | - | - |
| 15.6 | Arthrobacter psychrochitiniphilus | 0.107 ± 0.012 | 5 × 105 | 1.53 ± 0.26 | - | + | 35.7 ± 3.0 | - |
| 16.7 | Arthrobacter psychrochitiniphilus | - | - | - | - | + | - | - |
| 23.2 | Agreia sp. | 0.024 ± 0.001 | - | - | - | + | - | - |
| 24.4 | Pseudomonas yamanorum | 0.227 ± 0.029 | 106 | 3.11 ± 0.81 | + | + | - | + |
| 25.2 | Hafnia sp. | 0.139 ± 0.006 | 108 | 3.03 ± 0.28 | + | + | 544.0 ± 7.0 | + |
| 26.2 | Pseudomonas sp. | 0.188 ± 0.005 | 108 | 2.71 ± 0.51 | + | + | 46.1 ± 2.0 | - |
| 26.7 | Pseudarthrobacter sp. | 0.225 ± 0.042 | 106 | 2.57 ± 0.79 | + | - | - | - |
| 39.12 | Brachybacterium sp. | 0.058 ± 0.004 | 103 | 2.75 ± 0.34 | + | - | - | - |
| 40.1 | Kocuria salsicia | 0.262 ± 0.027 | 5 × 105 | 1.55 ± 0.27 | + | - | 21.3 ± 2.0 | - |
| Strain Number | Species Name | MTC, mg NaCl/L | GRR, % |
|---|---|---|---|
| 9.1 | Siminovitchia terrae | 10 | 89.71 |
| 10.1 | Pseudomonas salomonii | 3 | 25.17 |
| 10.4 | Psychrobacter arcticus | 10 | 85.47 |
| 15.6 | Arthrobacter psychrochitiniphilus | 10 | 80.76 |
| 16.7 | Arthrobacter psychrochitiniphilus | 10 | 94.09 |
| 23.2 | Agreia sp. | 10 | 79.40 |
| 24.4 | Pseudomonas yamanorum | 3 | 15.53 |
| 25.2 | Hafnia sp. | 6 | 42.03 |
| 26.2 | Pseudomonas sp. | 6 | 87.25 |
| 26.7 | Pseudarthrobacter sp. | 25 | 77.73 |
| 39.12 | Brachybacterium sp. | 10 | 84.99 |
| 40.1 | Kocuria salsicia | 20 | 55.74 |
| Fungal Strain | Inhibition of Fungal Growth, % | ||
|---|---|---|---|
| Arthrobacter psychrochitiniphilus 15.6 | Pseudomonas yamanorum 24.4 | Hafnia sp. 25.2 | |
| Nigrospora oryzae 15966 | 11.13 ± 1.73 | - | 18.30 ± 1.90 |
| Fusarium solani 50718 | 33.00 ± 8.00 | 20.33 ± 1.15 | - |
| Nectria inventa 3041 | - | 5.10 ± 0.21 | 21.85 ± 2.03 |
| Botrytis cinerea 16884 | 18.28 ± 1.58 | - | 18.90 ± 1.90 |
| Sclerotinia sclerotirum 16883 | 21.61 ± 2.13 | 11.43 ± 0.57 | - |
| Rhizoctonia solani 16036 | 5.96 ± 0.16 | 3.37 ± 0.2 | 20.08 ± 0.21 |
| Bacterial Strain | Biofilm Type | Average Biofilm Thickness (µm) | Structure Description |
|---|---|---|---|
| Siminovitchia terrae 9.1 | ALS * | 32 | Dispersed biofilm; cell aggregates are tightly intertwined with cellulose fibers; very low levels of amyloids |
| Pseudomonas salomonii 10.1 | ALS | ~20 | Dense biofilm; low content of cellulose; high content of amyloid proteins |
| Psychrobacter arcticus 10.4 | LS ** | 15 | Dense biofilm; low content of cellulose; low content of amyloid proteins |
| Arthrobacter psychrochitiniphilus 15.6 | LS | 45 | Mucous biofilm; biofilms are in the form of spherical aggregations; cells are tightly surrounded by cellulose; low amyloids |
| Hafnia sp. 25.2 | ALS | 5 | Dispersed biofilm; high cellulose content; cellulose in fibers intertwined with cells; low amyloid content |
| Pseudomonas sp. 26.2 | ALS | 35 | Mucous biofilm; high content of cellulose and amyloid proteins |
| Pseudarthrobacter sp. 26.7 | ALS | 20 | Mucous biofilm; cell aggregates are very dispersed; cellulose is located between cells, which are surrounded by a thin layer of amyloid proteins |
| Brachybacterium sp. 39.12 | LS | 7 | Dispersed biofilm; low cellulose content; very few amyloid proteins |
| Kocuria salsicia 40.1 | LS | 25 | Dense biofilm, with small dense aggregates of cells with fibers; few amyloid proteins |
Disclaimer/Publisher’s Note: The statements, opinions and data contained in all publications are solely those of the individual author(s) and contributor(s) and not of MDPI and/or the editor(s). MDPI and/or the editor(s) disclaim responsibility for any injury to people or property resulting from any ideas, methods, instructions or products referred to in the content. |
© 2024 by the authors. Licensee MDPI, Basel, Switzerland. This article is an open access article distributed under the terms and conditions of the Creative Commons Attribution (CC BY) license (https://creativecommons.org/licenses/by/4.0/).
Share and Cite
Iungin, O.; Prekrasna-Kviatkovska, Y.; Kalinichenko, O.; Moshynets, O.; Potters, G.; Sidorenko, M.; Savchuk, Y.; Mickevičius, S. Endophytic Bacterial Biofilm-Formers Associated with Antarctic Vascular Plants. Microorganisms 2024, 12, 1938. https://doi.org/10.3390/microorganisms12101938
Iungin O, Prekrasna-Kviatkovska Y, Kalinichenko O, Moshynets O, Potters G, Sidorenko M, Savchuk Y, Mickevičius S. Endophytic Bacterial Biofilm-Formers Associated with Antarctic Vascular Plants. Microorganisms. 2024; 12(10):1938. https://doi.org/10.3390/microorganisms12101938
Chicago/Turabian StyleIungin, Olga, Yevheniia Prekrasna-Kviatkovska, Oleksandr Kalinichenko, Olena Moshynets, Geert Potters, Marina Sidorenko, Yaroslav Savchuk, and Saulius Mickevičius. 2024. "Endophytic Bacterial Biofilm-Formers Associated with Antarctic Vascular Plants" Microorganisms 12, no. 10: 1938. https://doi.org/10.3390/microorganisms12101938
APA StyleIungin, O., Prekrasna-Kviatkovska, Y., Kalinichenko, O., Moshynets, O., Potters, G., Sidorenko, M., Savchuk, Y., & Mickevičius, S. (2024). Endophytic Bacterial Biofilm-Formers Associated with Antarctic Vascular Plants. Microorganisms, 12(10), 1938. https://doi.org/10.3390/microorganisms12101938

